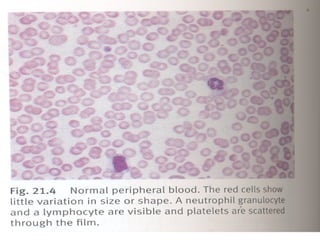
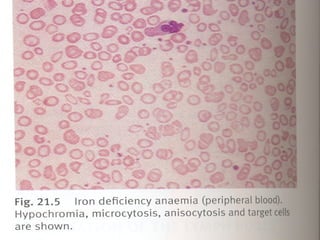
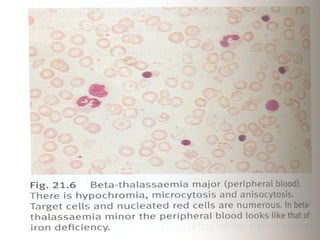
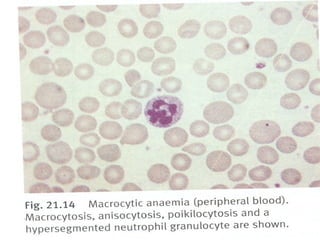

1) O documento discute o sistema hematopoiético e seus sintomas, incluindo anemias, poliglobulias e linfonodos.
2) Detalha a anamnese relevante para distúrbios hematológicos, incluindo histórico familiar, exposições e sintomas.
3) Fornece uma lista extensa de sinais e sintomas que podem ocorrer em vários órgãos devido a problemas hematológicos.